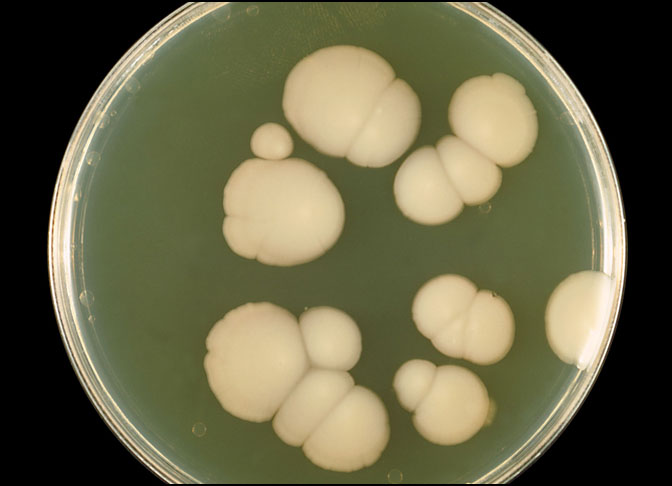

Candidiasis is an infection caused by Candida albicans, an opportunistic yeast that lives in our gastrointestinal tracts, also known as the ‘gut’.
The gut contains over 100 trillion microbes, also known as the ‘gut microbiota’.
Candida albicans is but one species that normally lives in harmony with the rest of the microbes in the gut microbiota.
When something upsets the balance within the gut microbiota, Candida albicans can multiply and spread, invading and infecting tissues. This infection, called Candidiasis, can spread anywhere along the GI tract, as well as infect the skin. Issues such as dandruff, thrush, and vaginal yeast infections are often caused by Candidiasis. It can also cause rashes, as well as ear and sinus infections.
Many things can cause the microbiota in our gut to become unbalanced, such as medical conditions and/or treatments that cause immunosuppression (ie HIV/AIDS, Diabetes, corticosteroids, THC, and antibiotic therapy). Candida albicans also loves sugar. Too much sugar in the diet and/or high blood glucose (ie. Diabetes) can ‘feed’ the yeast, causing it to spread.
In severely immunocompromised individuals, the yeast can even cross into the bloodstream or organs causing life-threatening systemic infection. Even though anti-fungal drugs and special diets exist to treat candidiasis, the infection can be difficult to get under control. Candida albicans can create biofilms that protect it from the body’s immune system and anti-fungal drugs, making it hard to kill.
And when Candida albicans does die it releases toxins into the body, which create inflammation. This is not a microbe that wants to go quietly.
Unfortunately, Candida albicans is a natural part of our gut and can’t be completely eliminated from the body, which makes managing Candida albicans a full-time job.
MY EXPERIENCE
Candidiasis first became a problem for me after I was diagnosed with Multiple Sclerosis. One of the MS treatments I was prescribed upset the balance in my gut microbiota, causing Candidiasis to occur. As a result, I was plagued with vaginal yeast infections, rashes, facial dandruff, ear and sinus infections, and thrush. Unfortunately, over-the-counter treatments and anti-fungal drugs weren’t a lot of help.
As a woman with MS, Candidiasis became a serious cause for concern because, like many things, it causes inflammation. When I discovered that inflammation can cause MS relapses, with relapses being the worsening of current or creation of new MS symptoms, I knew I had to get a handle on my Candidiasis.
I got the best results preventing/managing outbreaks of Candidiasis by limiting my sugar consumption, managing my Diabetes, and incorporating the following items into my beneficial diet:
Hydration and taking Activated Charcoal have also helped flush out toxins that can cause inflammation.
Managing my Candidiasis, and related toxins, helps me manage my MS.
UPDATES:
I tried CBD gummies in 2023, to help with sleep issues, unfortunately the THC in the gummies suppressed my immune system triggering a massive outbreak of Candidiasis. The outbreak took the form of a very large, extremely painful rash, that took over six months to get rid of.
-Jen, aka. Power Chair Dorothy
REFERENCES
Badet, C., Furiga, A., & Thébaud, N. (2008). Effect of Xylitol on an In Vitro Model of Oral Biofilm. Oral Health & Preventive Dentistry, 6, 337-41.
Cavalheiro, M., & Teixeira, M. C. (2018). Candida Biofilms: Threats, Challenges, and Promising Strategies. Frontiers in Medicine, 5, 28.
Cortinovis, C., & Caloni, F. (2016). Household Food Items Toxic to Dogs and Cats. Frontiers in Veterinary Science, 3, 26.
Donlan R. M. (2002). Biofilms: Microbial Life on Surfaces. Emerging Infectious Diseases, 8(9), 881–890.
Gow, N. A. R. and Yadav, B. (2017). Microbe Profile: Candida albicans: A Shape-changing, Opportunistic Pathogenic Fungus of Humans. Microbiology, 163(8), 1145-1147. doi: 10.1099/mic.0.000499.
Kumamoto C. A. (2011). Inflammation and Gastrointestinal Candida Colonization. Current Opinion in Microbiology, 14(4), 386–391.
Mayer, F. L., Wilson, D., & Hube, B. (2013). Candida albicans Pathogenicity Mechanisms. Virulence, 4(2), 119–128.
Nikou, S-A., Kichik, N., Brown, R., Ponde, N. O., Ho, J., Naglik, J. R., & Richardson, J. P. (2019). Candida albicans Interactions with Mucosal Surfaces during Health and Disease. Pathogens, 8(2) 53. doi: 10.3390/pathogens8020053.
Rafiee Zadeh, A., Askari, M., Azadani, N. N., Ataei, A., Ghadimi, K., Tavoosi, N., & Falahatian, M. (2019). Mechanism and Adverse Effects of Multiple Sclerosis Drugs: A Review Article. Part 1. International Journal of Physiology, Pathophysiology and Pharmacology, 11(4), 95–104.
Rodrigues, C. F., Rodrigues, M. E., & Henriques, M. (2019). Candida sp. Infections in Patients with Diabetes Mellitus. Journal of Clinical Medicine, 8(1), 76.
Singh, A., Verma, R., Murari, A., & Agrawal, A. (2014). Oral Candidiasis: An Overview. Journal of Oral and Maxillofacial Pathology, 18(Suppl 1), S81–S85.
Talattof, Z., Azad, A., Zahed, M., & Shahradnia, N. (2018). Antifungal Activity of Xylitol against Candida albicans: An in vitro Study. The Journal of Contemporary Dental Practice, 19(2), 12.
Not in Kansas Anymore (www.notinksanymore.com) is a site/blog authored and managed by Jen, aka. Power Chair Dorothy (pwrchr-dorothy). This site/blog is intended to provide educational and research information, and to share the author’s experiences.
The author of this site/blog is not a medical physician and this site/blog does not provide medical advice. This site/blog contains information that should not be used in place of a visit, call, consultation or the advice of your physician or other qualified healthcare provider. If you choose to apply or implement any information posted at this site/blog, you do so at your own risk.